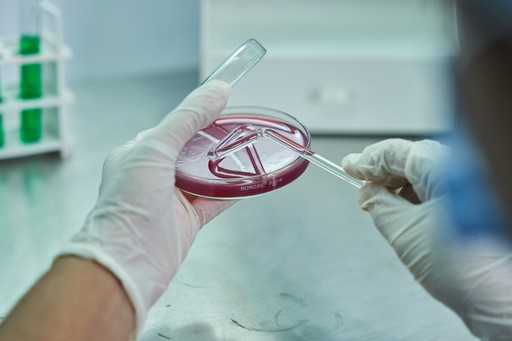

Infrastructure
Infrastructure








Resarch Lab
Research Lab
Research Lab

Environment, Health and Safety Campaign
Medical camp / Safety
Instruction camp
Environment, Health and Safety Campaign







Your Reliable Trusted Soluable Provider!

Your Reliable Trusted Soluable Provider!
